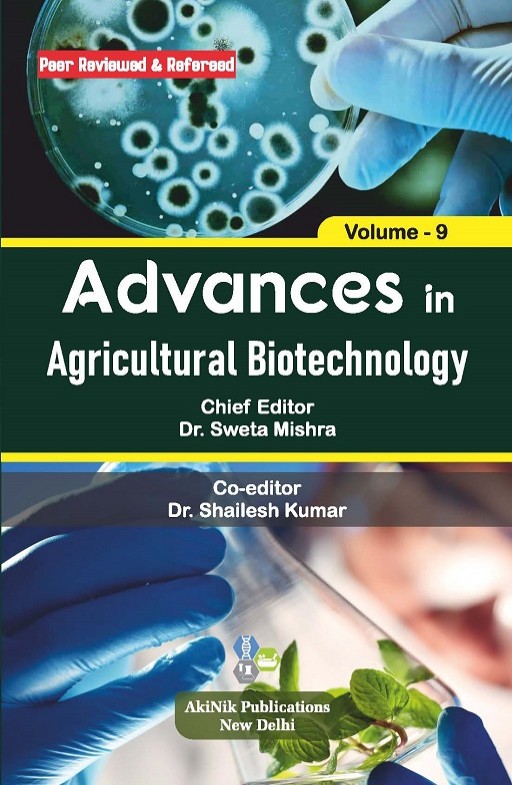
Advances in Agricultural Biotechnology (Volume - 9) Advances in Agricultural Biotechnology (Volume - 9)

| Chief Editor | : | Dr. Sweta Mishra |
| Co-editor(s) | : | Dr. Shailesh Kumar |
| Paperback ISBN | : | 978-93-5570-980-6 |
| Publisher | : | AkiNik Publications |
| Language | : | English |
| Pages | : | 135 |
| Publication Year | : | 2023 |
| Binding | : | Paperback |
| DOI | : | https://doi.org/10.22271/ed.book.2420 |



Somewhat challenging for newcomers to the field, but highly informative for experienced researchers.